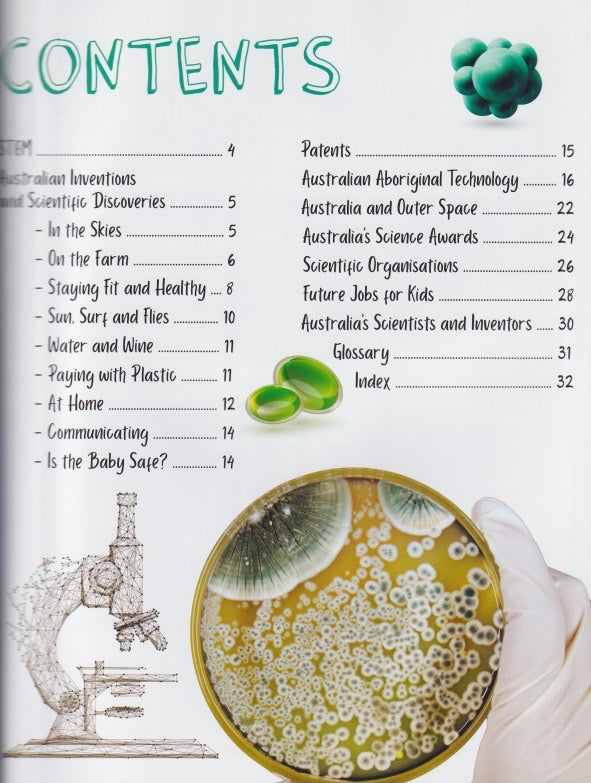
Fantastic Facts About: Australia's Amazing Inventions (Softcover)

Description
Author: Frances Payne
From the scientific discoveries made by the Indigenous Australians living thousands of years ago, right up to the wonders of Wi-Fi, the technology that Australians continue to invent is used by people around the world. Whether it's medicines from local plants, or ways to keep babies safe while travelling in cars, there are lots of inventions to find out about in this book.
How much do you really know about Australia? Did you know that the whole continent is on the
move, or that Aussies were the first to use penicillin? Dip in anywhere throughout this series to find
masses of mini articles on everything you could want to know about Australia.
Published: April 2021
Reading Level: 8+
Pages: 32
Format: Paperback
Publisher: Redback Publishing
Series: Fantastic Facts About
Product Category: Science / Science: Inventions
Australian Curriculum: Technologies - Design and Technology